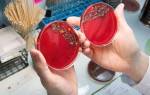

Анализ на уреаплазму предполагает выполнение лабораторных исследований. Они позволяют установить присутствие в организме возбудителей уреаплазмоза — урогенитальной инфекции. К уреаплазмам относят три вида микроорганизма – уреаплазму парвум, уреаплазму специес и уреаплазму уреалитикум.
Как берут анализ на уреаплазму у мужчин?
Материалом для исследования может быть:
- мазок из уретрального канала
- ротовой полости
- ануса
- кровь
- моча
- семенная жидкость
- сок простаты
Мазок из уретры берут с помощью одноразового стерильного зонда. Для этого мужчине за 1,5-2 ч до забора материала следует воздержаться от мочеиспускания, а за неделю – отказаться от приема каких-либо антибиотиков.
Подготовка к анализу на уреаплазму у мужчин
также включает в себя воздержание от сексуальных контактов за 2-3 суток до взятия биоматериала.
В день визита к врачу до исследования не следует подмываться и использовать какие-либо средства антимикробного действия для обработки гениталий.
Как сдается анализ на уреаплазму у мужчин
если для этого необходима кровь или моча? Для исследования пациент сдает кровь из локтевой вены утром на голодный желудок. За день до забора крови следует отказаться от приема алкоголя, а также употребления жирной, жареной и острой пищи. Для исследования мочи необходима ее первая утренняя порция, собранная в стерильный аптечный контейнер.
Урогенитальный мазок может быть использован для ПЦР-исследования или культурального посева. В ходе полимеразной цепной реакции происходит обнаружение в биологическом субстрате генома или фрагментов ДНК возбудителя инфекции. Высокая точность и информативность этого вида исследования обеспечивается за счет его высочайшей чувствительности.
В результате уреаплазмы обнаруживаются даже при их минимальной концентрации в исследуемом образце. Уреаплазмы являются условно патогенными микробами. Однако, обнаружение их в ходе исследования в образце является поводом для назначения курса лечения. Так как рано или поздно накопление критичной массы возбудителя в тканях урогенитального тракта приведет к развитию инфекционно-воспалительного процесса.
Бактериологическое исследование биоматериала, взятого от пациента, дает возможность определить присутствие инфекционного агента в его организме. А так же выяснить, к каким антимикробным препаратам он проявляет восприимчивость. Исследование предполагает выращивание колоний микроорганизмов в специальных условиях в термостате в течение нескольких дней.
После чего становится возможным их идентификация и верификация диагноза.
Анализ мочи на уреаплазму у мужчин
проводится с помощью ПЦР или культурального посева. Он может проводиться в тех случаях, когда пациент против забора мазка из мочеиспускательного канала.
Выявление уреаплазмоза в организме больного возможно также с помощью иммунодиагностики – для этого используются серологические реакции. Диагностический механизм основан на выявлении в сыворотке крови пациента антител, образованных к уреаплазме.
Иммуноглобулины к уреаплазме начинают выявляться в крови не раньше, чем через 14 дней после инфицирования. Обнаружение иммуноглобулинов класса А и М означает либо свежее заражение в острой фазе течения. Либо активацию возбудителя и обострение инфекционно-воспалительного процесса в виде рецидива.
Выявление иммуноглобулинов класса G означает, что заболевание перешло в хроническую форму.
Анализ на уреаплазму необходим при появлении признаков урогенитальной инфекции – нарушений мочеиспускания, жжения, боли в уретре, нехарактерных слизистых выделений и т.д.
При необходимости сдать анализы на уреаплазму у мужчин обращайтесь в нашу клинику.
| Стоимость услуги: | 450 руб.* Заказать |
Срок исполнения: 1 — 3 к.д.
- Микоплазмы, комплексное исследование (Ureaplasma parvum, Ureaplasma urealyticum, Mycoplasma hominis), количественное определение ДНК (соскоб и др.) 1050 руб. Метод исследования: ПЦР ДНК U.urealyticum / U.parvum / M.hominis – прямой маркер наличия этих возбудителей в урогенитальном тракте. Тест проводится в количественном формате и позволяет оценить степень обсемененности урогенитального тракта условно-патогенными . Заказать
Заказать В составе комплекса дешевле Указанный срок не включает день взятия биоматериала
Условия подготовки определяются лечащим врачом.
ВНИМАНИЕ: для получения достоверных результатов, анализы на выявление возбудителей бактериальных инфекций должны проводиться не ранее, чем через 2 недели после последнего приема антибактериальных препаратов. Взятие соскобов для ПЦР-диагностики проводится во всех офисах CMD.
Не рекомендуется взятие биоматериала ранее 24-48 часов после полового контакта.
Соскоб из урогенитального тракта (у мужчин): рекомендуется сдавать через 2 часа после последнего мочеиспускания.
Соскоб из урогенитального тракта (у женщин): мазки не следует брать:
- во время менструации;
- ранее 5 дней после использования вагинальных свечей, тампонов или спермицидов;
- после вагинального исследования (УЗИ малого таза, кольпоскопия), спринцевания;
» [«opisanie»]=> string(3810) «
Метод исследования: ПЦР
ДНК U.urealyticum / U.parvum – прямой маркер наличия возбудителей в урогенитальном тракте. Тест позволяет определить степень обсемененности урогенитального тракта уреаплазмами. Ureaplasma spp. – условно-патогенные микроорганизмы, патогенные свойства проявляют при определенных условиях. Уреаплазмы могут выявляться у клинически здоровых лиц. Уреаплазмы способны вызывать уретрит у мужчин (U. urealyticum), цервицит, цистит, воспалительные заболевания органов малого таза (ВЗОМТ), а также осложнения течения беременности, послеродовые и послеабортные осложнения. До настоящего времени не получено достаточного количества данных о причинной связи генитальных уреаплазм со спонтанными абортами и невынашиванием беременности. В то же время, при отягощенном акушерско-гинекологическом анамнезе целесообразно выявление и лечение.
ПОКАЗАНИЯ К ИССЛЕДОВАНИЮ:
- Обследование при наличии клинико-лабораторных признаков воспалительного процесса в области урогенитального тракта при отсутствии других патогенных возбудителей
- Обследование доноров спермы
- Обследование пациентов с невынашиванием беременности, с диагнозом бесплодие
ИНТЕРПРЕТАЦИЯ РЕЗУЛЬТАТОВ:
Референсные значения (вариант нормы):
Параметр Референсные значения Единицы измерения Количество ДНК Ureaplasma parvum / Ureaplasma urealyticum Не обнаружено копии/мл
Выявление ДНК U.urealyticum / U. parvum свидетельствует о наличии возбудителей. При оценке результатов необходимо учитывать, что уреаплазмы U.urealyticum / U. parvum условно-патогенные микроорганизмы и в небольшой концентрации могут присутствовать у здоровых лиц.
Обращаем Ваше внимание на то, что интерпретация результатов исследований, установление диагноза, а также назначение лечения, в соответствии с Федеральным законом № 323-ФЗ «Об основах охраны здоровья граждан в Российской Федерации» от 21 ноября 2011 года, должны производиться врачом соответствующей специализации.
» [«serv_cost»]=> string(3) «450» [«cito_price»]=> NULL [«parent»]=> string(2) «25» [10]=> string(1) «1» [«limit»]=> NULL [«bmats»]=> array(1) < [0]=>array(3) < [«cito»]=>string(1) «N» [«own_bmat»]=> string(2) «12» [«name»]=> string(12) «Соскоб» > > [«within»]=> array(1) < [0]=>array(5) < [«url»]=>string(82) «mikoplazmy-kompleksnoje-issledovanije-kolichestvennoje-opredelenije-dnk-pcr_170002» [«name»]=> string(217) «Микоплазмы, комплексное исследование (Ureaplasma parvum, Ureaplasma urealyticum, Mycoplasma hominis), количественное определение ДНК (соскоб и др.)» [«serv_cost»]=> string(4) «1050» [«opisanie»]=> string(6959) «
Метод исследования: ПЦР
ДНК U.urealyticum / U.parvum / M.hominis – прямой маркер наличия этих возбудителей в урогенитальном тракте. Тест проводится в количественном формате и позволяет оценить степень обсемененности урогенитального тракта условно-патогенными микоплазмами.
Ureaplasma urealyticum, Ureaplasma Parvum и Mycoplasma hominis – условно-патогенные микроорганизмы, патогенные свойства проявляют при определенных условиях.
Ureaplasma urealyticum, Ureaplasma Parvum и Mycoplasma hominis могут выявляться у клинически здоровых лиц. Уреаплазмы способны вызывать уретрит у мужчин (U. urealyticum), цервицит, цистит, ВЗОМТ (воспалительные заболевания органов малого таза), а также осложнения течения беременности, послеродовые и послеабортные осложнения.
Микоплазма у женщин: до настоящего времени не получено достаточного количества данных о причинной связи генитальных микоплазм со спонтанными абортами и невынашиванием беременности. В то же время, при отягощенном акушерско-гинекологическом анамнезе целесообразно выявление и лечение.
ПОКАЗАНИЯ К ИССЛЕДОВАНИЮ:
- Обследование при наличии клинико-лабораторных признаков воспалительного процесса в области урогенитального тракта при отсутствии других патогенных возбудителей
- Обследование доноров спермы
- Обследование пациентов с невынашиванием беременности, с диагнозом бесплодие
ИНТЕРПРЕТАЦИЯ РЕЗУЛЬТАТОВ:
Референсные значения (вариант нормы):
| Параметр | Референсные значения | Единицы измерения |
|---|---|---|
| Количество ДНК Ureaplasma parvum | Не обнаружено | копии/мл |
| Количество ДНК Ureaplasma urealyticum | Не обнаружено | копии/мл |
| Количество ДНК Mycoplasma hominis | Не обнаружено | копии/мл |
Выявление ДНК Ureaplasma urealyticum / Ureaplasma Parvum / Mycoplasma hominis свидетельствует о наличии возбудителей. Кроме того, тест позволяет определить концентрацию возбудителей, что имеет важное значение при решении вопроса о назначении лечения.
При оценке результатов необходимо учитывать, что условно-патогенные микоплазмы (Ureaplasma urealyticum, Ureaplasma Parvum и Mycoplasma hominis) в небольшой концентрации могут присутствовать у здоровых лиц.
Кроме того при обследовании и для диагностики урогенитальной патологии анализа на условно-патогенные микоплазмы Ureaplasma urealyticum / Ureaplasma Parvum / Mycoplasma hominis часто бывает недостаточно — необходимо использовать более широкий спектр исследований, а у женщин — обязательно определять количественное соотношение микрофлоры влагалища:
Выбор исследования зависит от диагностических целей — обращайтесь к своему лечащему врачу.
Обращаем Ваше внимание на то, что интерпретация результатов исследований, установление диагноза, а также назначение лечения, в соответствии с Федеральным законом № 323-ФЗ «Об основах охраны здоровья граждан в Российской Федерации» от 21 ноября 2011 года, должны производиться врачом соответствующей специализации.
» [«catalog_code»]=> string(6) «170002» > > >
Биоматериал и доступные способы взятия: Тип В офисе Соскоб Подготовка к исследованию:
Условия подготовки определяются лечащим врачом.
ВНИМАНИЕ: для получения достоверных результатов, анализы на выявление возбудителей бактериальных инфекций должны проводиться не ранее, чем через 2 недели после последнего приема антибактериальных препаратов. Взятие соскобов для ПЦР-диагностики проводится во всех офисах CMD.
Не рекомендуется взятие биоматериала ранее 24-48 часов после полового контакта.
Соскоб из урогенитального тракта (у мужчин): рекомендуется сдавать через 2 часа после последнего мочеиспускания.
Соскоб из урогенитального тракта (у женщин): мазки не следует брать:
- во время менструации;
- ранее 5 дней после использования вагинальных свечей, тампонов или спермицидов;
- после вагинального исследования (УЗИ малого таза, кольпоскопия), спринцевания;
Метод исследования: ПЦР
ДНК U.urealyticum / U.parvum – прямой маркер наличия возбудителей в урогенитальном тракте. Тест позволяет определить степень обсемененности урогенитального тракта уреаплазмами. Ureaplasma spp. – условно-патогенные микроорганизмы, патогенные свойства проявляют при определенных условиях. Уреаплазмы могут выявляться у клинически здоровых лиц. Уреаплазмы способны вызывать уретрит у мужчин (U. urealyticum), цервицит, цистит, воспалительные заболевания органов малого таза (ВЗОМТ), а также осложнения течения беременности, послеродовые и послеабортные осложнения. До настоящего времени не получено достаточного количества данных о причинной связи генитальных уреаплазм со спонтанными абортами и невынашиванием беременности. В то же время, при отягощенном акушерско-гинекологическом анамнезе целесообразно выявление и лечение.
ПОКАЗАНИЯ К ИССЛЕДОВАНИЮ:
- Обследование при наличии клинико-лабораторных признаков воспалительного процесса в области урогенитального тракта при отсутствии других патогенных возбудителей
- Обследование доноров спермы
- Обследование пациентов с невынашиванием беременности, с диагнозом бесплодие
ИНТЕРПРЕТАЦИЯ РЕЗУЛЬТАТОВ:
Референсные значения (вариант нормы):
| Параметр | Референсные значения | Единицы измерения |
|---|---|---|
| Количество ДНК Ureaplasma parvum / Ureaplasma urealyticum | Не обнаружено | копии/мл |
Выявление ДНК U.urealyticum / U. parvum свидетельствует о наличии возбудителей. При оценке результатов необходимо учитывать, что уреаплазмы U.urealyticum / U. parvum условно-патогенные микроорганизмы и в небольшой концентрации могут присутствовать у здоровых лиц.
Обращаем Ваше внимание на то, что интерпретация результатов исследований, установление диагноза, а также назначение лечения, в соответствии с Федеральным законом № 323-ФЗ «Об основах охраны здоровья граждан в Российской Федерации» от 21 ноября 2011 года, должны производиться врачом соответствующей специализации.
Продолжая использовать наш сайт, вы даете согласие на обработку файлов cookie, пользовательских данных (сведения о местоположении; тип и версия ОС; тип и версия Браузера; тип устройства и разрешение его экрана; источник откуда пришел на сайт пользователь; с какого сайта или по какой рекламе; язык ОС и Браузера; какие страницы открывает и на какие кнопки нажимает пользователь; ip-адрес) в целях функционирования сайта, проведения ретаргетинга и проведения статистических исследований и обзоров. Если вы не хотите, чтобы ваши данные обрабатывались, покиньте сайт.
Copyright ФБУН Центральный НИИ Эпидемиологии Роспотребнадзора, 1998 — 2019
! Продолжая использовать наш сайт, вы даете согласие на обработку файлов cookie, пользовательских данных (сведения о местоположении; тип и версия ОС; тип и версия Браузера; тип устройства и разрешение его экрана; источник откуда пришел на сайт пользователь; с какого сайта или по какой рекламе; язык ОС и Браузера; какие страницы открывает и на какие кнопки нажимает пользователь; ip-адрес) в целях функционирования сайта, проведения ретаргетинга и проведения статистических исследований и обзоров. Если вы не хотите, чтобы ваши данные обрабатывались, покиньте сайт.
Информация об исследовании
Уреаплазма уреалитикум
Полимеразная цепная реакция (ПЦР) позволяет увеличить число копий ДНК бактерий или вирусов в миллионы раз с использованием фермента ДНК-полимеразы. Для диагностики достаточно одной молекулы ДНК. Синтезированное количество ДНК идентифицируют методами иммуноферментного анализа или электрофореза. ПЦР-диагностика позволяет обнаружить возбудителя на самых ранних этапах инфекционного процесса, в любой биологической среде организма, с возможностью количественного определения вирусов или бактерий. Уреаплазма уреалитикум относится к условно-патогенным микроорганизмам, вызывают воспалительные заболевания урогенитального тракта. Уреаплазмы определяют в моче, отделяемом из уретры или цервикального канала, из влагалища, в соке предстательной железы.
Уреаплазма уреалитикум — уникальный представитель микрофлоры человека, занимающий промежуточное положение между вирусами и бактериями. Уреаплазма — внутриклеточный паразит, относящийся к семейству микоплазм. Это самые мелкие из свободно живущих микроорганизмов, лишенные клеточной стенки. С бактериями микроб схож некоторыми особенностями обмена веществ, а с вирусами – генетическим аппаратом и размером. Согласно общепринятым медицинским нормам, у женщин ureaplasma urealyticum является условно-патогенным микроорганизмом,(т.е. возможно бессимптомное носительство) проявляющим свои болезнетворные свойства лишь под воздействием неблагоприятных факторов (болезни половых органов, снижение иммунной защиты, половые инфекции,воспаление простаты, иммунодефициты и нарушение факторов местной защиты, дисбиоз влагалища у женщин.). В ассоциации с другими патогенными или условно-патогенными микробами уреаплазма может привести к развитию целого ряда патологий, требующих лечения. В большинстве случаев данный микроорганизм отличается высокой устойчивостью к современным антибиотикам и с трудом поддается терапии
Показания к назначению исследования
Подготовка к исследованию
С этим исследованием сдают
- 16.1. Гинекологический мазок на флору
- 16.2. Мазок на флору из уретры
- 120.4. Посев отделяемого урогенитального тракта на микрофлору
- 172.0. Посев на уреаплазму уреалитикум и микоплазму хоминис
Результаты исследования
Факторы, влияющие на результаты исследований
Интерпретация результата
Положительный результат — обнаружено
В исследуемом образце обнаружены ДНК возбудителя. Выявление ДНК при симптомах воспаления и отсутствии патогенных возбудителей свидетельствует о наличии специфической инфекции. Если ДНК возбудителей выявляется в небольшом количестве у людей без признаков патологии органов мочеполовой системы, это расценивается как носительство
Отрицательный результат — не обнаружено
Не найдено фрагментов ДНК, специфичных для исследуемых возбудителей или концентрация возбудителя в образце ниже границы чувствительности теста.